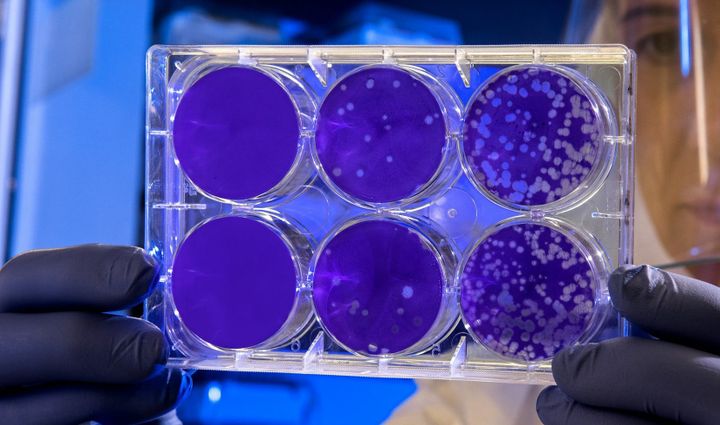
Gut-brain axis I: Gut bacteria and brain health

Men at + 50, testosterone and mental health
Testosterone is a vital hormone that plays a key role in male health. And yes there is - as suspected - a direct pathway between the testes and the brain.
Testosterone is produced mainly in the testes and acts as the primary male sex hormone. Beyond these well-known sexual functions, testosterone